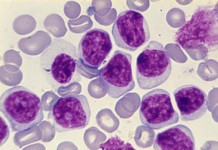

Архив
Особые методы переливания крови
Для лечения некоторых болезней применяется особый метод переливания крови, называемый гемаферезом. Гемаферез (гемосорбция, плазмосорбция) — это процесс очистки. Он заключается в том, что у человека...
Железодефицитная анемия
Что такое железодефицитная анемия? Железодефицитная анемия развивается при недостатке в организме железа. Железо – элемент, который играет чрезвычайно важную роль в доставке органам кислорода. Железо входит...
Как справиться с хроническим миелолейкозом
Хронический миелолейкоз: фазы и лечение
Болезни крови
Краткий обзор наиболее распространенных заболеваний системы крови.
Анемии
Обзор основных типов анемий с перечислением симптомов.
Исследования костного мозга
Верный способ найти причину патологии клеток крови – исследование образца костного мозга. Взятие костного мозга осуществляется двумя путями. Либо путем аспирации, или отсасывания через широкую...
Неходжкинские лимфомы – побочные эффекты лечения
На любом этапе лечения неходжкинской лимфомы можно облегчить побочные эффекты и осложнения. Если врач назначил лекарственные препараты для устранения некоторых симптомов, необходимо придерживаться...